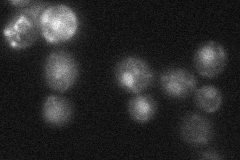

View description
Acetyl-coA synthetase isoform which, along with Acs2p, is the nuclear source of acetyl-coA for histone acetlyation; expressed during growth on nonfermentable carbon sources and under aerobic conditions
Localization:
Intensity:
Fold change:
Significance:
-
C’ GFP library in SD

nucleus23.86 -
N' NOP1pr-GFP in SD

cytosol,nucleus133.768 -
N' TEF2pr-mCherry in SD

ER,vacuoleN/A -
N' NATIVEpr-GFP in SD
nucleus20.9454 -
N' TEF2pr-VC and Cyto-VN in SD

nucleus77.1272 -
C’ GFP library in SD+DTT

nucleusN/AN/ANo -
C’ GFP library in SD+H2O2

nucleusN/AN/ANo -
C’ GFP library in Starvation Media

nucleusN/AN/AYes -
C’ GFP library on the background of Pup2-DaMP

nucleus -
C’ GFP library on the background of CCT mutant

nucleusN/AN/ANo
